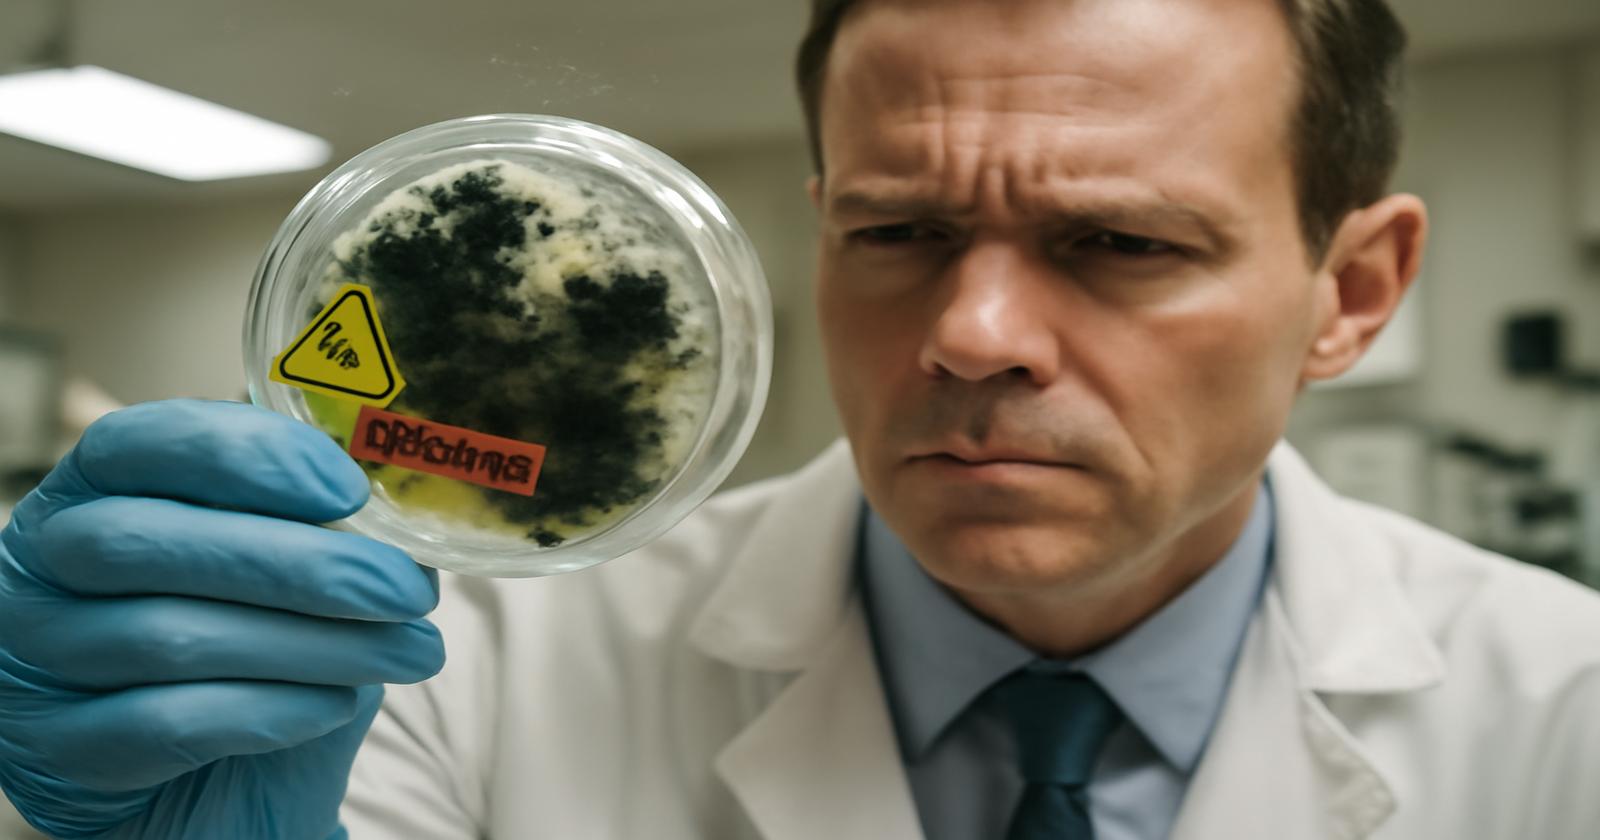

Es beginnt mit einem süßlichen, fast unmerklichen Geruch. Feucht, warm, ein Hauch von Erde nach Sommerregen. Du würdest ihn vielleicht “wohlig” nennen, würdest tiefer einatmen, ohne zu ahnen, dass jede deiner Atemzüge winzige Sporen in deine Lunge trägt. Sie sind unsichtbar, lautlos, geduldig. Und während der Wasserdampf langsam an der Fensterscheibe herabrinnt, weben sie bereits ihr eigenes, tödliches Netz.
Schimmel war lange Zeit das, was wir mit vergessenen Brotlaiben und muffigen Kellerabteilen verbindet haben – ein hygienisches Problem, ein optischer Makel. Heute taucht er in den Schlagzeilen auf: als globaler Gesundheitsfeind, als lautlose Invasion in Krankenhäuser, Wohnungen, Wälder, ja in ganze Ökosysteme. Ärzte auf mehreren Kontinenten verwenden plötzlich Wörter wie “Klimawandel”, “resistent” und “unheilbar”, wenn sie über Pilze sprechen. Das klingt wie Science-Fiction – wäre da nicht der sehr reale Geruch im eigenen Badezimmer.
Wenn die Luft zur Gefahr wird
Stell dir vor, du wachst morgens mit einem leichten Kratzen im Hals auf. Kein Grund zur Sorge – vielleicht ist die Luft zu trocken, vielleicht kommt eine Erkältung. Doch das Kratzen bleibt. Es verwandelt sich in Husten, manchmal begleitet von einem seltsamen Druck auf der Brust. Nach ein paar Wochen fühlst du dich erschöpft, als hättest du schlecht geschlafen – jede Nacht. Du nimmst es hin, es ist eben der Stress, sagst du dir. Was du nicht siehst: Mit jedem Atemzug bahnen sich winzige Pilzsporen ihren Weg tief in deine Lungenbläschen.
Schimmelpilze sind Meister der Tarnung. Sie schweben in der Luft, haften an Vorhängen, Teppichen, Klimaanlagenfiltern, an der Topfpflanzenerde auf deiner Fensterbank. Sie lieben Feuchtigkeit, Wärme und organisches Material – und unser moderner Lebensstil liefert ihnen all das im Überfluss. Dicht gedämmte Häuser, schlecht gelüftete Badezimmer, subtropische Feuchtigkeit in Städten, in denen es früher kalt und trocken war. Während wir unsere Wohnungen energieeffizienter machen, schaffen wir unbewusst Brutkammern für Pilze.
In den Lungen eines gesunden Menschen räumt das Immunsystem normalerweise gründlich auf. Doch die Spielregeln haben sich geändert. Immer mehr Menschen leben mit chronischen Erkrankungen, bekommen Chemotherapien, Immunsuppressiva, Biologika, oder erholen sich von Virusinfektionen, die ihre Abwehr schwächen. Für viele dieser Menschen ist ein Pilzbefall kein Randproblem mehr, sondern eine reale Gefahr – manchmal sogar tödlich.
Neue Killer aus dem Reich der Pilze
Die meisten von uns kennen Pilze als Champignons in der Pfanne oder als Flecken an der Wand. Doch im Schatten dieser Alltagserfahrungen hat sich eine stille Evolution vollzogen. Einige Pilzarten haben begonnen, sich an ein wärmeres Klima und an unsere modernen Medikamente anzupassen – und sie treten immer aggressiver auf.
Ein Name fällt dabei immer häufiger: Candida auris. Vor wenigen Jahrzehnten kannte ihn kaum jemand, heute sorgt dieser Hefepilz weltweit für Alarmmeldungen in Kliniken. Er überlebt auf Metalloberflächen, auf Bettgittern, auf medizinischen Geräten – selbst auf gründlich geputzten Stationen. Er liebt die trockene Kühle von Intensivstationen genauso wie die feuchte Wärme auf unserer Haut. Das Beunruhigende: Viele seiner Stämme sind resistent gegen gängige Antipilzmittel. Wenn er in den Blutkreislauf gelangt, kann er Organe befallen, Sepsis auslösen – und innerhalb weniger Tage tödlich enden.
Noch heimtückischer sind Pilze aus der Gattung Aspergillus, besonders Aspergillus fumigatus. Seine Sporen sind überall in der Umwelt: in Komposthaufen, Blumenerde, staubiger Luft, auf Baustellen. Wir atmen sie täglich ein, meist ohne es zu merken. Doch in den Lungen von Menschen mit vorgeschädigtem Gewebe – etwa nach einer schweren Grippe, Covid-19, Asthma oder COPD – können sie eine invasive Aspergillose auslösen: ein aggressives Wachstum von Pilzfäden, die sich durch Lungengewebe bohren, Blutgefäße angreifen und sich im Körper ausbreiten.
Ärzte berichten von Patientinnen und Patienten, deren Lungenbilder aussehen, als hätte ein Gewitter aus weißem Nebel ihre Bronchien gefüllt. Jeder Atemzug ist ein Kampf, jede Nacht ein Ringen um Sauerstoff. Antipilzmittel schlagen nicht immer an, manche Pilzstämme sind bereits resistent. Und während Bakterieninfektionen oft innerhalb von Tagen eskalieren, sind Pilzinfektionen zäh, langwierig und schwer zu fassen. Sie passen nicht zu unseren schnellen, klaren Erklärungen von krank und gesund. Sie sind eher wie eine langsame, unerbittliche Erosion.
Der unsichtbare Verstärker: Klimawandel
Warum jetzt? Warum scheint die Welt plötzlich von tödlichen Pilzen zu sprechen? Ein zentrales Puzzleteil ist der Klimawandel. Pilze sind extrem anpassungsfähig, aber sie haben natürliche Grenzen – vor allem bei der Temperatur. Die Körpertemperatur des Menschen war lange eine Art Schutzschild: Vielen Umweltpilzen ist es in unseren 36–37 Grad schlicht zu heiß, um ernsthafte Infektionen auszulösen.
Doch während sich die Durchschnittstemperaturen der Erde erhöhen, verschieben sich auch die Anpassungsgrenzen der Pilze. Arten, die früher nur in tropischen Regionen überlebten, finden nun in gemäßigten Zonen ideale Bedingungen. Andere entwickeln die Fähigkeit, höhere Temperaturen zu tolerieren – und kommen damit näher an die menschliche Körpertemperatur heran. Was gestern noch ein harmloser Bodenpilz war, könnte morgen ein potenzieller Krankheitserreger sein.
Hinzu kommt: Extreme Wetterereignisse wie Fluten, Hurricanes und Starkregen zerstören Infrastruktur, überfluten Häuser, durchfeuchten Wände, Teppiche und Möbel. Nach einer Flutkatastrophe bleibt oft ein kaum sichtbares Erbe zurück: Schimmelsporen, die sich im Mauerwerk festsetzen und Monate später fröhlich sprießen, wenn der Alltag schon längst wieder eingekehrt scheint.
Wie der Mensch dem Schimmel beim Starkwerden hilft
Die globale Pilzgefahr ist kein Naturphänomen, das losgelöst von uns existiert. Im Gegenteil: Viele ihrer Ursachen liegen direkt in unserem Handeln. Ein leiser, aber entscheidender Faktor ist der Einsatz von Fungiziden in der Landwirtschaft.
Auf riesigen Feldern werden Pilzgifte gespritzt, um Getreide, Obst und Gemüse vor Schimmelbefall zu schützen. Ein Teil dieser Stoffe ist chemisch eng verwandt mit Medikamenten, die in der Humanmedizin gegen Pilzinfektionen eingesetzt werden. Für Pilze bedeutet das: Sie kommen draußen auf den Feldern bereits mit diesen Wirkstoffen in Berührung und beginnen, Abwehrstrategien zu entwickeln. Wenn einzelne resistente Pilzstämme überleben, vermehren sie sich und breiten ihre Fähigkeiten aus. Erreichen diese Pilze irgendwann die Lungen eines geschwächten Patienten, trifft die Medizin dann auf einen Gegner, der das Arsenal schon kennt.
Auch unsere Gebäudekultur spielt eine Rolle. Luftdichte Fenster, schlecht belüftete Badezimmer, falsch geplante Dämmung: Was Energie spart, kann Feuchtigkeit in Wänden und Ecken einschließen. Manchmal reicht ein minimaler Wasserschaden – eine undichte Leitung hinter der Wand, eine falsch abgedichtete Dusche –, damit sich hinter Tapeten ein mikroskopischer Urwald bildet. Erst sind nur kleine, graue Schatten zu sehen, dann dunklere Flecken, später ein faseriger Belag: ein sichtbares Symptom einer unsichtbaren Überbevölkerung.
In Krankenhäusern spitzt sich das Problem zu. Hier treffen die schlimmsten Bedingungen aufeinander: Menschen mit extrem geschwächtem Immunsystem, invasive Eingriffe, Katheter, Schläuche, Beatmungsgeräte. Wenn sich in solchen Umgebungen ein widerstandsfähiger Pilz etabliert, gleicht das einem Brand im Trockenwald: Er breitet sich still aus, von Patient zu Patient, von Oberfläche zu Oberfläche. Ärzte sprechen von “Ausbrüchen”, als würde es sich um Flammen handeln, die man einzudämmen versucht, bevor sie das gesamte Haus erfassen.
Wie Ärzte überhaupt erkennen, was da wächst
Pilzinfektionen sind heimtückisch, auch weil sie diagnostisch schwer zu fassen sind. Während Bakterieninfektionen schnell mit einem Abstrich und einer Kultur identifiziert werden können, braucht es für Pilze oft mehr Geduld – und moderne Labortechnik.
In vielen Kliniken reicht ein klassischer Abstrich nicht mehr. Die Kulturen brauchen Tage, manchmal Wochen. In dieser Zeit kann ein aggressiver Pilz bereits lebensbedrohliche Schäden anrichten. Deswegen greifen Ärzteteams zunehmend auf molekulare Methoden zurück: Sie suchen in Blut- oder Gewebeproben nach DNA-Spuren spezifischer Pilzarten, fast so, als würden sie an einem Tatort Genmaterial aufspüren. Winzige Mengen genetischer Information werden vervielfältigt, bis klar wird: Ist es Aspergillus? Candida? Oder ein völlig anderer Eindringling, der bisher kaum beschrieben ist?
Doch selbst mit moderner Diagnostik bleibt ein Dilemma: Pilze wachsen langsam, resistent gewordene Arten reagieren träge oder gar nicht auf Standardtherapien. Manchmal müssen Ärzte auf Verdacht behandeln, weil jede Stunde zählt. In diesen Momenten wird die Arbeit am Krankenbett zu einer Mischung aus Wissenschaft, Erfahrung und Intuition – und eine Erinnerung daran, wie unvollständig unser Wissen über das Reich der Pilze noch ist.
Symptome, die wir gern wegwischen
Auch fernab der Intensivstation spielt Schimmel eine unterschätzte Rolle. Viele Menschen leben in Wohnungen, in denen kleine schwarze oder grüne Flecken entlang von Fensterrahmen oder hinter Schränken wachsen. Ein feuchter Geruch im Schlafzimmer, leichtes Brennen in den Augen am Morgen, eine ständig laufende Nase – das wird oft als Allergie, Staubempfindlichkeit oder “Wintererkältung” abgetan.
Die Beschwerden sind meistens unspektakulär: Kopfschmerzen, Müdigkeit, Reizhusten, Schlafprobleme, Hautjucken. Weil sie sich nicht dramatisch anfühlen, bleiben sie selten mit der Wohnsituation verknüpft. Viele merken erst nach einem Umzug, wie sehr der alte Schimmel sie beeinflusst hat – wenn plötzlich die Nase frei ist und die Erschöpfung nachlässt. Ärzte warnen: Besonders für Kinder, Ältere und Menschen mit Asthma oder Immunschwäche kann eine latent verschimmelte Wohnung ein permanenter Stressfaktor für den Körper sein.
Die Herausforderung: Schimmel ist nicht immer sichtbar. Er kann sich hinter Tapeten, unter Fußböden, in Lüftungsschächten ausbreiten. Der Körper reagiert aber oft schon, bevor das Auge etwas wahrnimmt. So entsteht eine unscharfe Zone, in der die Betroffenen ihre Symptome nicht ernst nehmen und Vermieter oder Hausverwaltungen die Gefahr herunterspielen – bis ein Gutachten oder eine drastische Verschlimmerung der Beschwerden Klarheit bringt.
| Warnsignal | Was dahinterstecken kann | Wann handeln? |
|---|---|---|
| Dauerhusten, besonders in Innenräumen | Reizung durch Schimmelsporen, Allergie, beginnende Infektion | Bei Beschwerden über Wochen ärztlich abklären, Wohnung prüfen lassen |
| Wiederkehrende Atemwegsinfekte | Chronische Belastung durch Innenraumschimmel | Medizinische Abklärung, besonders bei Kindern und Älteren |
| Muffiger Geruch ohne sichtbare Flecken | Versteckter Feuchtigkeitsschaden, Schimmel hinter Wänden | Bausachverständige oder Schimmelgutachter hinzuziehen |
| Verschlechterung von Asthma oder Allergien zu Hause | Sensibilisierung auf Schimmelpilze | Allergietest, Wohnungssanierung prüfen |
Zwischen Respekt und Panik: Wie viel Angst ist angemessen?
Bei all den Warnungen ist eine Frage zentral: Wie groß ist die Gefahr wirklich? Ärzte und Forscher wählen ihre Worte sorgfältig. “Tödlicher Schimmel” ist eine dramatische Formulierung, aber sie beschreibt nur einen kleinen Teil des Spektrums. Für gesunde Menschen mit stabilem Immunsystem bleibt das Risiko schwerer Pilzinfektionen vergleichsweise gering. Wer sich ausgewogen ernährt, ausreichend schläft, chronische Erkrankungen behandeln lässt und nicht dauerhaft in stark verschimmelten Räumen lebt, hat in der Regel gute Karten.
Dennoch ist Leichtsinn fehl am Platz. Tödliche Pilzinfektionen betreffen vor allem Menschen, die ohnehin schon verletzlich sind: Krebspatienten, Menschen nach Organtransplantationen, sehr alte oder schwerkranke Personen, aber auch manche Diabetiker oder Menschen mit schweren Lungenerkrankungen. Für sie kann ein Pilz, den andere nebenbei wegatmen, zur tödlichen Gefahr werden.
Darum geht es bei den warnenden Stimmen aus der Medizin nicht um Panik, sondern um Bewusstsein. Es ist ein Aufruf, das Reich der Pilze ernst zu nehmen – als Teil unserer Umwelt, als unsichtbaren Mitbewohner, aber eben auch als potenziellen Krankheitserreger. Und um ein Eingeständnis: Unsere Werkzeuge im Kampf gegen resistente Pilze sind begrenzt, neue Medikamente sind rar, die Entwicklung dauert Jahre. Vorbeugung ist deshalb kein netter Bonus, sondern unsere stärkste Waffe.
Was du konkret tun kannst
Zwischen globaler Klimakrise und Krankenhausstatistik gehen manchmal die einfachen, praktischen Schritte im Alltag verloren. Doch genau hier beginnt dein persönlicher Schutz vor Schimmelrisiken – im Kleinen, im Routinierten.
➡️ Psychotrick hinter Textnachrichten: Was Handy-Schreiber wirklich gemeinsam haben
➡️ Vergiss teure Avocados: Dieses Balkon-Gemüse macht deinen Toast genauso cremig
➡️ Olympia 2026: Wie Eiskunstläufer ihr Gehirn gegen Schwindel trainieren
➡️ Im Erdkern steckt genug Wasserstoff für Dutzende Ozeane
➡️ Sport auf leeren Magen: Hilft das wirklich beim Fettabbau?
➡️ Heizen mit Obstabfall: Wie eine irre Erfindung Kaminholz ersetzen soll
➡️ Italienisches Bergdorf zahlt 20.000 Euro fürs Hinziehen – das sind die Bedingungen
Regelmäßiges Lüften ist mehr als ein Tipp aus Großmutters Zeiten. Mehrmals täglich für einige Minuten querzulüften, also gegenüberliegende Fenster zu öffnen, lässt Feuchtigkeit entweichen und reduziert die Chance, dass sich Schimmel in Ecken festsetzt. Badezimmer sollten nach dem Duschen gut durchlüftet werden; feuchte Wände trocknen schneller, wenn die Luft zirkuliert. Wäsche besser nicht dauerhaft in Wohnräumen trocknen, vor allem nicht in schlecht gelüfteten Schlafzimmern.
Möbel an Außenwänden brauchen ein wenig Abstand – fünf bis zehn Zentimeter können schon reichen, damit Luft dahinter zirkulieren kann. Kondenswasser an Fenstern im Winter sollte abgewischt und nicht ignoriert werden, es ist ein kleiner Hinweis darauf, dass die Luftfeuchtigkeit zu hoch ist. Wenn sich Schimmelflecken zeigen, gehört mehr dazu, als sie mit Farbe zu überstreichen: Die Ursache der Feuchtigkeit muss gefunden und behoben werden.
Wer zu Risikogruppen gehört – etwa aufgrund von Krebsbehandlung, Transplantation, schweren Lungenerkrankungen oder anderen Immunschwächen – sollte mit seinem Ärzteteam über das persönliche Pilzrisiko sprechen. Manchmal sind zusätzliche Vorsichtsmaßnahmen sinnvoll: Schutzmasken in staubiger Umgebung, Meiden von frisch umgeschichteten Komposthaufen, Vorsicht mit Zimmerpflanzenerde, sorgfältige Hygiene zu Hause.
Eine stille Revolution im Hintergrund
Während du diese Zeilen liest, arbeiten in Laboren weltweit Forscherinnen und Forscher an der Frage, wie wir mit der globalen Pilzgefahr umgehen können. Sie untersuchen, wie Pilze Resistenzen entwickeln, wie sich ihre Gene verändern, wie sie auf steigende Temperaturen reagieren. Sie testen neue Substanzen, kombinieren alte Wirkstoffe, entwickeln Diagnoseverfahren, die binnen Stunden statt Tagen Ergebnisse liefern sollen.
Gleichzeitig wird im öffentlichen Gesundheitswesen diskutiert, wie der Einsatz von Fungiziden in der Landwirtschaft klüger gestaltet werden kann, um Resistenzen zu bremsen. Architekten und Bauingenieure überlegen, wie sich Energieeffizienz mit Schimmelschutz besser vereinen lässt. Stadtplaner beschäftigen sich mit der Frage, wie sich Wohnquartiere an feuchtere, heißere Sommer anpassen können, ohne zu Brutstätten für Pilze zu werden.
All das geschieht leise, im Hintergrund. Keine Sirenen, keine blinkenden Lichter. Nur das stetige Summen von Laborgeräten, das Rascheln von Papier auf Konferenzen, das Tippen von Daten in Computer. Es passt irgendwie zum Wesen der Pilze selbst: unspektakulär auf den ersten Blick, tiefgreifend in ihrer Wirkung.
Vielleicht ist das die größte Herausforderung: unsere Vorstellung zu ändern. Pilze sind nicht nur die freundlichen Helfer, die Brot backen und Bier brauen, nicht nur die bunten Kappen am Waldboden. Sie sind auch Gegner, die wir kaum kennen, die sich verändern, während wir noch dabei sind, sie zu verstehen. “Tödlicher Schimmel” ist ein Schlagwort, aber dahinter steckt eine komplexe Geschichte über unser Verhältnis zur Umwelt, zu unserem Körper, zu den unsichtbaren Mitbewohnern dieser Erde.
Und doch liegt in dieser Geschichte auch eine Chance. Denn alles, was wir über Pilze lernen, zeigt uns, wie eng wir mit der Welt um uns herum verflochten sind. Jeder Atemzug, jede Wand, jede Gartenhandvoll Erde erinnert daran, dass wir nicht getrennt von diesem stillen Netzwerk leben, sondern mittendrin. Vielleicht ist der erste Schritt zur Vorsorge nicht die Angst, sondern der Respekt – und die Bereitschaft, genauer hinzusehen, wenn der süßliche Geruch im Badezimmer plötzlich etwas eindringlicher wird als sonst.
FAQ: Häufige Fragen zu tödlichem Schimmel und Pilzgefahren
Kann Schimmel in der Wohnung wirklich tödlich sein?
In den meisten Fällen führt Wohnungsschimmel nicht direkt zum Tod. Er kann aber chronische Atemwegsbeschwerden, Allergien und Asthma verschlimmern und das Immunsystem belasten. Für Menschen mit stark geschwächter Abwehr kann eine dauerhafte Belastung das Risiko schwerer Infektionen erhöhen.
Wie erkenne ich, ob Schimmel mir gesundheitlich schadet?
Typische Anzeichen sind anhaltender Husten, verstopfte oder laufende Nase, Atemnot, Kopfschmerzen, brennende Augen, Müdigkeit und Verschlechterung bestehender Allergien oder Asthma – vor allem, wenn die Symptome hauptsächlich zu Hause auftreten. Ein Arztbesuch und ggf. Allergietests können Klarheit bringen.
Reicht es, sichtbaren Schimmel einfach zu überstreichen?
Nein. Überstreichen kaschiert nur das Problem. Die eigentliche Ursache – Feuchtigkeit durch falsches Lüften, bauliche Mängel oder Wasserschäden – muss behoben werden. Kleinere befallene Flächen können mit geeigneten Mitteln entfernt werden, größere Schäden sollten Fachleute sanieren.
Bin ich als gesunder Mensch von tödlichen Pilzen bedroht?
Schwere, lebensbedrohliche Pilzinfektionen betreffen vor allem Menschen mit stark geschwächtem Immunsystem. Gesunde Personen erkranken wesentlich seltener, sollten aber Schimmel in Wohnräumen dennoch ernst nehmen, um chronische Beschwerden zu vermeiden.
Was kann ich tun, um mich und meine Familie zu schützen?
Regelmäßig und richtig lüften, Feuchtigkeit schnell beseitigen, Möbel nicht direkt an kalte Außenwände stellen, Wasserschäden rasch beheben und auffällige Schimmelflecken nicht ignorieren. Bei wiederkehrenden Beschwerden in der Wohnung ärztlichen Rat einholen und die Räume fachkundig prüfen lassen.
Warum sprechen Ärzte von einer globalen Pilz-Gefahr?
Klimawandel, zunehmende Resistenzen durch Fungizide, mehr immungeschwächte Patienten und weltweite Mobilität führen dazu, dass aggressive Pilzarten sich schneller ausbreiten und schwerer behandelbar werden. Das macht Pilzerkrankungen zu einem wachsenden Thema der globalen Gesundheit.
Hilft eine FFP2-Maske auch gegen Pilzsporen?
FFP2-Masken können die Menge der eingeatmeten Partikel, einschließlich vieler Pilzsporen, deutlich reduzieren und bieten insbesondere für Risikopatienten in staubiger oder potenziell belasteter Umgebung einen zusätzlichen Schutz. Sie ersetzen aber keine Sanierung von Schimmelquellen in Innenräumen.